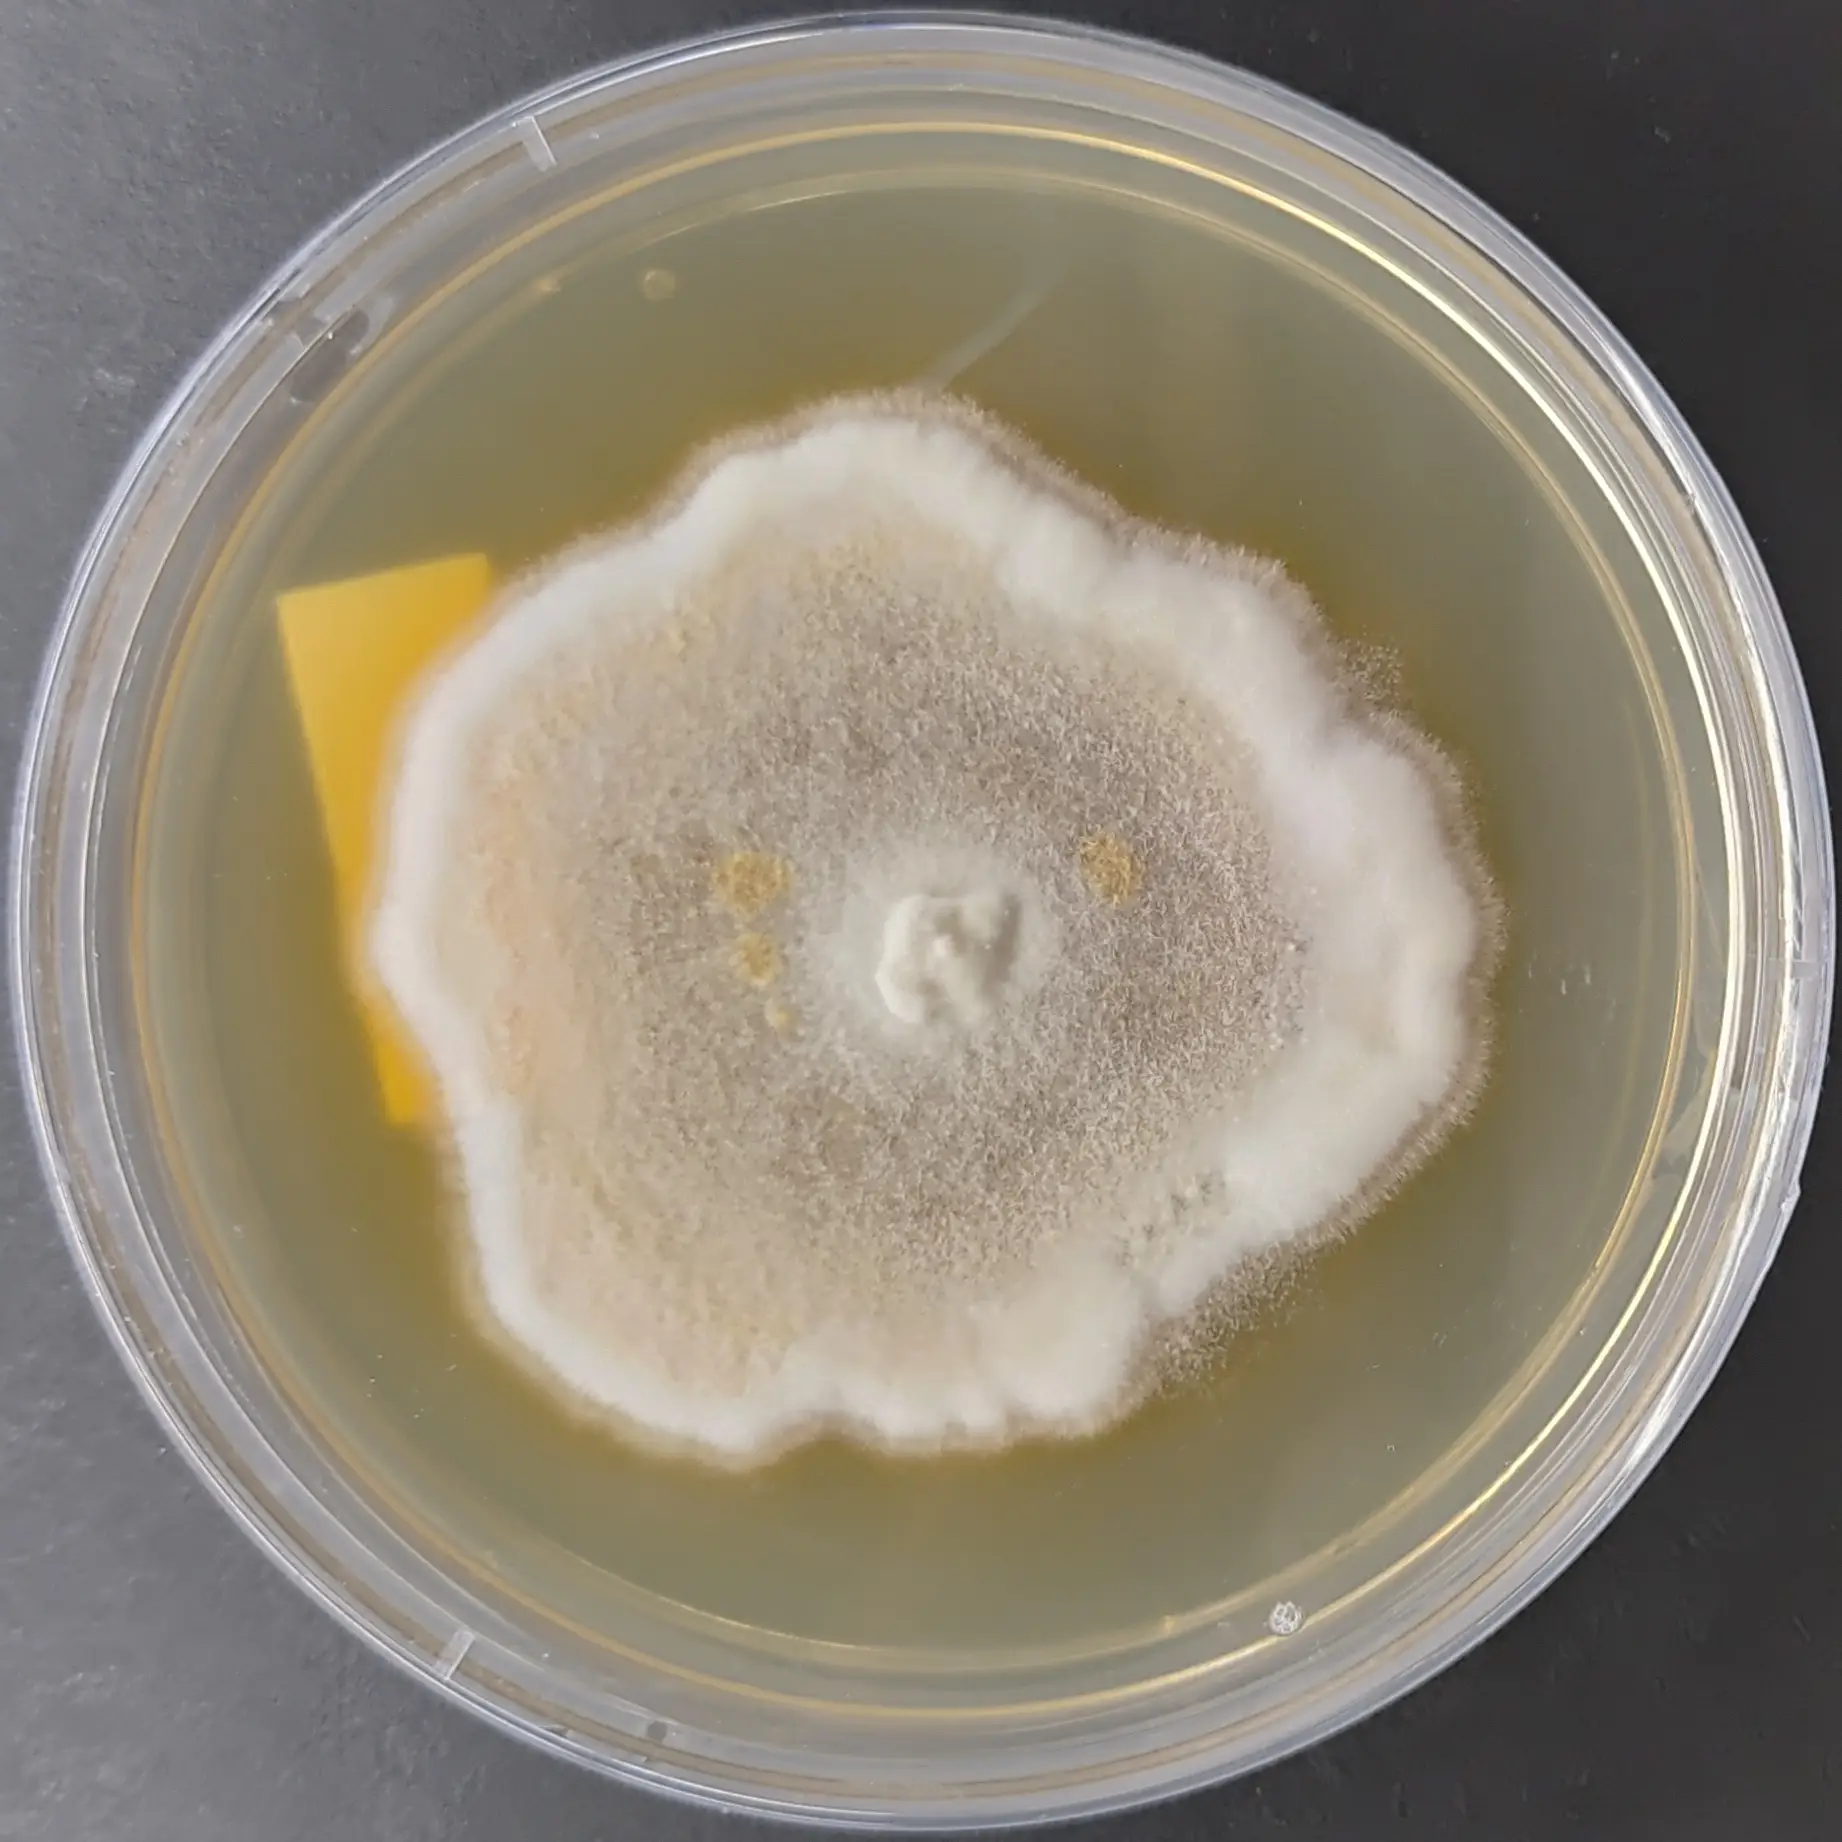
F88 Ischnoderma resinosum.webp

Lignosus rhinocerus Pure Culture (Tiger milk mushroom)
₹2,500.00
You’re now subscribed to price tracking for this product. We’ll notify you if the price drops.
The Lignosus rhinocerus Pure Culture from Agripie is a high-purity, axenic fungal culture prepared under controlled laboratory conditions for research, strain preservation, and medicinal mushroom biotechnology. Lignosus rhinocerus, commonly known as the Tiger Milk Mushroom, is a rare tropical polypore traditionally used in Southeast Asian ethnomedicine and extensively studied for its immunomodulatory polysaccharides, bioactive proteins, and therapeutic potential.
This culture is developed through single-source tissue isolation, ensuring genetic stability, consistent colony morphology, and freedom from bacterial or fungal contamination. On agar media, the mycelium typically shows white to creamy-white growth, compact to slightly cottony texture, and moderate radial expansion under optimal incubation conditions.
The culture adapts well to nutrient-balanced agar media and is suitable for maintenance cultures, sub-culturing, metabolite studies, sclerotial research, and controlled cultivation trials. Due to its rarity and medicinal relevance, L. rhinocerus is primarily used in academic research, pharmaceutical R&D, and advanced mushroom biotechnology programs, rather than conventional commercial farming.
🧪 Culture Specifications
-
Scientific Name: Lignosus rhinocerus
-
Common Name: Tiger Milk Mushroom
-
Culture Type: Pure (axenic) culture
-
Format: Agar culture plate
-
Plate Size: 90 mm sterile Petri plate
-
Isolation Method: Single-source lab isolation
-
Quality Control: Visual contamination screening before dispatch
🌱 Growth Characteristics
-
Mycelial Color: White to creamy white
-
Texture: Compact to slightly cottony
-
Growth Rate: Moderate
-
Preferred Media: PDA, MEA, specialized medicinal mushroom media
🌡️ Optimal Incubation Parameters
-
Temperature: 22–28 °C
-
pH Range: 5.5–6.5
-
Light Requirement: Dark to low light
-
Humidity: Standard laboratory incubation conditions
🔬 Applications
-
Medicinal mushroom and pharmacological research
-
Polysaccharide and bioactive compound studies
-
Sclerotium development research
-
Academic teaching and strain preservation
Storage: Store at 42–8 °C. Sub-culture within 3 months for optimal culture vigor.
Intended Use: Research and educational purposes only. Not intended for direct consumption.
| Weight | 0.1 g |
|---|
Only logged in customers who have purchased this product may leave a review.

Reviews
There are no reviews yet.